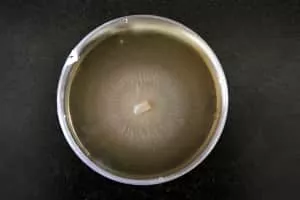

Ophiostoma
| Use attributes for filter ! | |
| Scientific name | Ophiostoma |
|---|---|
| Order | Ophiostomatales |
| Rank | Genus |
| Higher classification | Ophiostomataceae |
| Kingdom | Fungi |
| Date of Reg. | |
| Date of Upd. | |
| ID | 2267951 |
About Ophiostoma
Ophiostoma is a genus of fungi within the family Ophiostomataceae. It was circumscribed in 1919 by mycologists Hans Sydow and Paul Sydow.